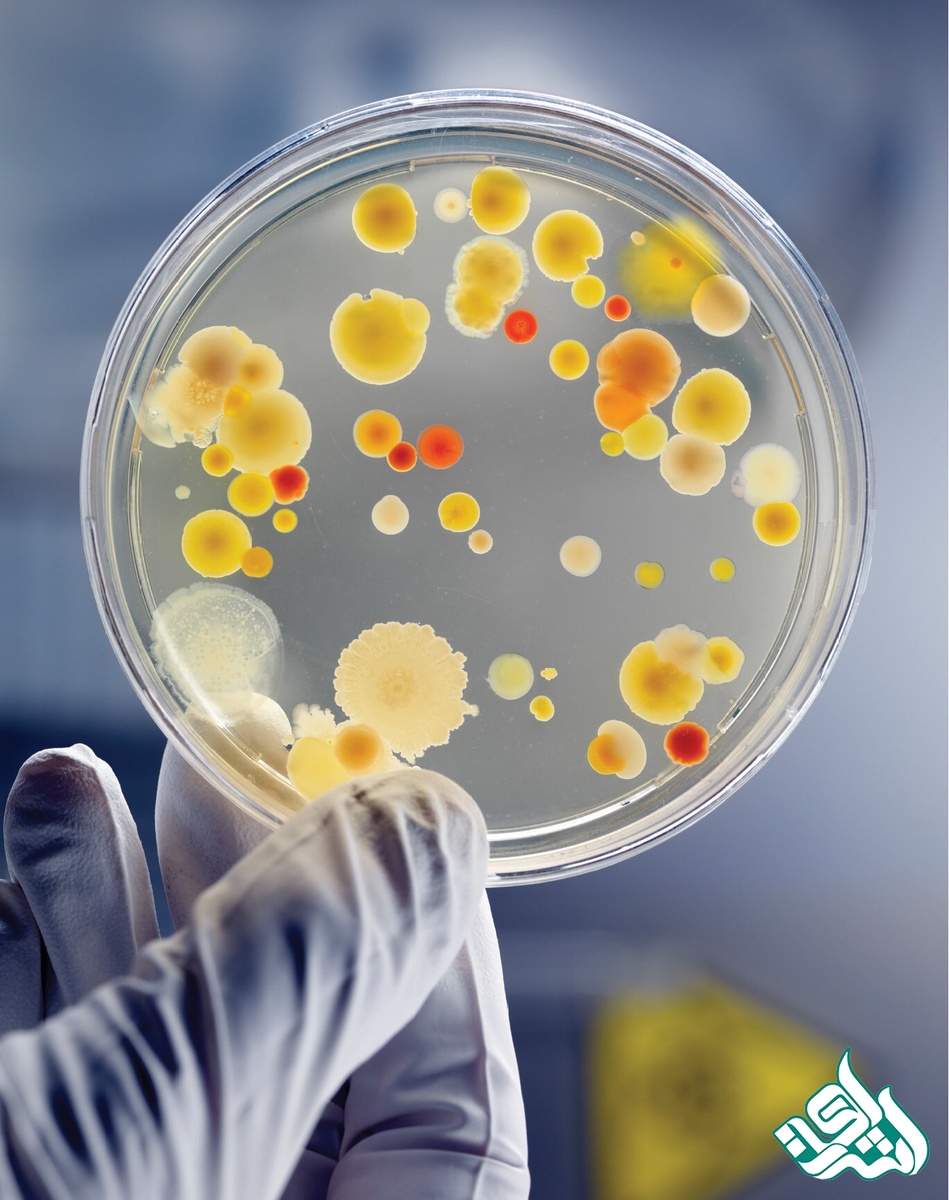
میکوبیولوژی

شبکه مترجمین اشراق: میکروبیولوژی، مطالعه میکروارگانیسمها یا میکروبها، یک گروه متنوع از فرمهای ساده زندگی که شامل باکتریها، جلبکها، قارچها، تکیاختهها و ویروسها است. این زمینه به ساختار، عملکرد و طبقهبندی چنین موجوداتی و همچنین روشهای بهرهبرداری و کنترل فعالیتهای آنها مربوط میشود.
در قرن هفدهم کشف موجودات زنده موجود با چشم غیرمسلح، یک نقطه عطف مهم در تاریخ علم بود، زیرا از قرن سیزدهم به بعد فرض بر این بود که موجودات «نامرئی» مسئول پوسیدگی و بیماری هستند. کلمه میکروب در آخر قرن نوزدهم برای توصیف این ارگانیسمها ابداعشده است که تصور میشد همه آنها با هم مرتبط هستند. ازآنجاکه سرانجام میکروبیولوژی به یک علم تخصصی تبدیل شد، مشخص شد که میکروبها گروه بسیار بزرگی از ارگانیسمهای بسیار متنوع هستند.
زندگی روزمره بهطور جداییناپذیری با میکروارگانیسمها درهمتنیده شده است. میکروبها علاوه بر جمعیت سطح داخلی و خارجی بدن انسان، در خاک، دریاها و هوا زیاد هستند. میکروارگانیسمها ازنظر ارزش زیست غیرقابل محاسبه با محیطزیست زمین، از هم پاشیدن بقایای حیوانات و گیاهان و تبدیل آنها به مواد سادهتر قابل بازیافت در موجودات دیگر استفاده میکنند.

میکروبیولوژی در اصل با توسعه میکروسکوپ آغاز شد. اگرچه ممکن است دیگران قبل از او میکروبهایی دیده باشند، اما آنتونی ون لیوونوئک، یک پارچهفروش هلندی بود که سرگرم ساخت عدسیها و میکروسکوپها بود، اولین کسی بود که مستندات مناسبی از مشاهدات خود ارائه داد. توضیحات و نقشههای او شامل تکیاختههای حاصل از روده حیوانات و باکتریها از خراش دندانها بود. سوابق وی عالی بود زیرا وی عدسیهای باکیفیت و استثنایی تولید میکرد. لیوونوئک یافتههای خود را در سلسله نامههایی به انجمن سلطنتی انگلیس در اواسط دهه 1670 انتقال داد. اگرچه مشاهدات وی علاقه زیادی را برانگیخت، اما هیچکس تلاش جدی برای تکرار آنها نکرد.
یونانیان اولیه معتقد بودند که موجودات زنده میتوانند از ماده غیرزنده (سوء زایمان) سرچشمه بگیرند. ارسطو این مفهوم را کنار گذاشت، اما او همچنان اعتقاد داشت که حیوانات میتوانند بهصورت خودبهخود از موجودات غیر متمایز یا از خاک ایجاد شوند. تأثیر وی در مورد این مفهوم از تولید خودبهخود هنوز در اواخر قرن 17 احساس شد، اما در اواخر آن قرن زنجیرهای از مشاهدات، آزمایشها و استدلالها آغاز شد که درنهایت این ایده را رد کرد.
اگرچه فرانسیسکو ردی، یک پزشک ایتالیایی، در سال 1668 رد کرد که اشکال بالاتر زندگی میتوانند بهطور خودبهخودی سرچشمه بگیرند، طرفداران این مفهوم ادعا میکردند که میکروبها متفاوت هستند و درواقع از این طریق به وجود میآیند. اسامی مشهور مانند جان نیدام و لازارو اسپالانزانی در اواسط دهه 1700 با این بحث مخالف بودند. در اوایل دهه 1800، فرانتس شولز و تئودور شوآن چهرههای اصلی در تلاش برای رد تئوریهای سوءاستفاده از بیماری بودند تا اینکه لوئی پاستور سرانجام نتایج آزمایشهای نهایی خود را در 1864 اعلام کرد که میکروبها میتوانند میکروبهای دیگری ایجاد کنند (بیوژنز). دانش مدرن و دقیق از اشکال باکتریها را میتوان به فردیناند کوهن، گیاهشناس آلمانی نسبت داد که نتایج اصلی آن بین سالهای 1853 و 1892 منتشر شده است. طبقهبندی باکتریهای کوهن که در سال 1872 منتشر شد و در سال 1875 تمدید شد، پسازآن بر مطالعه این ارگانیسمها تسلط یافت.

گیرولام فراکاستورو، یک محقق ایتالیایی، این ایده را در اواسط دهه 1500 پیش گرفت که واگیری، عفونتی است که از یک چیز به چیز دیگر منتقل میشود. رابرت کچ، یک پزشک آلمانی، این آزمایش را برای اثبات اینکه یک ارگانیسم خاص باعث یک بیماری خاص میشود، تعریف کرد. پایه و اساس میکروبیولوژی در حدود 1880 تا 1900 گذاشته شد. دانشجویان پاستور، کچ و دیگران با موفقیت سریع تعداد زیادی از باکتریها را قادر به ایجاد بیماریهای خاص (پاتوژن ها) کردند. آنها همچنین یک منبع وسیع از تکنیکها و روشهای آزمایشگاهی را برای آشکار شدن همه چربی، تنوع و توانایی میکروبها ارائه دادند.
همه این تحولات در اروپا رخ داده است. در اوایل دهه 1900، میکروبیولوژی در آمریکا تأسیس شد. بسیاری از میکروبیولوژیستها که در این زمان در آمریکا کار میکردند، یا تحت کوچ یا در انستیتوی پاستور در پاریس تحصیلکرده بودند. پس از تأسیس در آمریکا، میکروبیولوژی بهخصوص با توجه به رشتههای مرتبط مانند بیوشیمی و ژنتیک رونق گرفت. در سال 1923 باکتریشناس آمریکایی دیوید برگی ثابت کرد که مرجع اصلی علم، نسخههای بهروز شده امروزه همچنان مورداستفاده قرار میگیرد. از دهه 1940 میکروبیولوژی دورهای بسیار پرباری را تجربه کرده است که طی آن بسیاری از میکروبهای ایجادکننده بیماری شناساییشده و روشهایی برای کنترل آنها ایجادشده است. میکروارگانیسمها نیز بهطور مؤثر در صنعت مورداستفاده قرارگرفتهاند. فعالیتهای آنها به حدی جهت دار شده است.
ویرایش یکی از مهمترین بخشهای یک مقاله یا متون میباشد زیرا با ویرایش تخصصی و حرفهای میتوان کیفیت یک مقاله یا متون را بالا برد. شما میتوانید با سفارش متون خود به ویراستاران شبکه مترجمین اشراق کیفیت متون خود را چند برابر کنید.